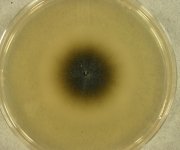

Search Details
| UAMH Number: | 10046 |
|---|---|
| Species Name: | Phaeoacremonium krajdenii |
| Type: | |
| Synonyms: | |
| Taxonomy: | FUNGI Ascomycota, Sordariomycetes, Togniniales, Togniniaceae |
| Strain History: | CDC B-6093 -> UAMH |
| Substrate: | white grain mycetoma, male 46 yr, histology + for white grains | Location: | INDIA Belgaum (GEO: 15.871,74.516) |
| Isolator: | |
| Isolation Date: | 2001 |
| Date Received: | 2001-08-17 |
| Characters: | HUMAN/ ANIMAL PATHOGEN eumycetoma - Hemashettar BM et al, J Clin Microbiol 2006 (in press) // MOLECULAR SYSTEMATICS formerly treated under Phialophora inflatipes - Mostert et al., J. Clin. Microbiol. 43:1752-1767, 2005 (Click for publications citing UAMH 10046) |
| Compounds: | |
| Cross Reference: | CBS 110361 // CDC 2001-00-8993 |
| Collections: | Living Strains; Dried Herbarium Material |
| Pathogenic Potential: | Human: yes | Animal: no | Plant: yes |
| Biosafety Risk Group: | RG2 (check the PHAC ePATHogen Risk Group Database for updates) |
| Regulatory Requirements: | Canadian requesters must provide PHAC Pathogen and Toxin License Number (see: https://www.canada.ca/en/public-health/services/laboratory-biosafety-biosecurity/licensing-program.html) prior to shipment. International requesters must provide all legally required importation documentation prior to shipment. Plant pathogenicity status may be verified by using the USDA Agricultural Research Service (ARS) Fungal Database |
| MycoBank ID: | 334052 |
| Sequences: | >UAMH10046_AY579270_actin TATGTGCAAGGCCGGTTTCGCCGGTGATGATGCTCCTCGAGCTGTTTTCCGTAAGTTCCCCCGCATCCGCACATCGCGCTCACAGATTTTCTCCAAAGAAAGCCTCTTGGGCCAGCGCAAGAGCCAAATCTGACCTCTCGCTAGCCTCCATTGTCGGTCGCCCCCGTCATCATGGGTAAGTCTCTCGTTCCGCTCTATCGGCCGAGCTCCCGCTGATGTTCTCCGTAGTATCATGATTGGTATGGGCCAGAAGGACTCGTA >UAMH10046_AY579333_bTub CCCCTGAGTTACCCCACCATCAATCACCTCACGATCACCGCCCTCGAGAGCTTGGACGACCTCGACGAGTCTCGATTGTAAACCCAAATCATCGATCAGTTTGCTAACCGGCGTCTTTTTTCACTTCAATAGGTTCACCTCCAGACCGGCCAATGCGTAAGTAGCTATTGCCACTCCTCATTCCGGGACACGTCTAACGATCTGTAGGGTAACCAAATCGGTGCTGCTTTCTGGTGCGTAGCTCCTCGAGCCGGCAACAAAACCCGCGAGACAGCCGTCGCGACATCGATACTGACTCTCATCTCAGGCAAACCATCTCTGGCGAGCACGGCCTCGACAGCAATGGCGTGTATGTGCCAATCGCCACCTTCCTCTTGTCGTGTTCACCGCTCTGACCTTGATATAGCTACAATGGCACCTCCGAGCTCCAGCTCGAGCGCATGAGCGTCTACTTCAACGAGGTATGCGAAAGCCACTCCTCCGTACCCCAGTCATGCAATGATTTTGTATGGACAGGATCTGATTCCTTTGCTTGTAGGCTTCCGGCAACAAGTAT |
IMAGES: